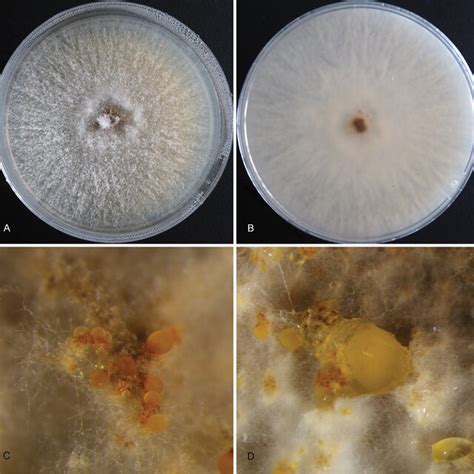

Psevdo-Cryoryase: A Deep Dive
Psevdo-Cryoryase: A Deep Dive
Psevdo-Cryoryase, guys, is a fascinating enzyme that’s been making waves in the scientific community. Its primary role revolves around catalyzing reactions that involve cryo-processes , essentially breaking down or modifying molecules at very low temperatures. Think of it as a specialized molecular scissor, but one that only works when things get really chilly. This unique characteristic sets it apart from many other enzymes and opens up a whole world of potential applications, from industrial processes to understanding biological functions in extreme environments. We’re going to dive deep into what makes this enzyme tick, why it’s so important, and where the research is heading.
Table of Contents
The Nitty-Gritty of Psevdo-Cryoryase’s Functionality
So, how does psevicroryase actually work its magic? Well, unlike many enzymes that thrive in the warm, cozy conditions of a typical cell, psevicroryase is adapted to function optimally in environments where temperatures hover around or below freezing. This isn’t just a minor quirk; it’s a fundamental aspect of its structure and catalytic mechanism. Scientists believe that the enzyme’s active site, the region where the chemical reaction takes place, is specifically designed to maintain its shape and flexibility even at these frigid temperatures. This involves a unique amino acid composition and potentially special bonding arrangements that resist the stiffening effect that cold typically has on proteins. When a substrate molecule, the one that the enzyme acts upon, binds to this active site, the enzyme can then perform its catalytic function. The ‘cryo’ part of its name highlights this extreme cold adaptation, and the ‘ryase’ suffix typically indicates an enzyme that catalyzes a lysis reaction, meaning it breaks a bond. Therefore, psevicroryase is an enzyme that breaks down molecules at low temperatures . This ability is incredibly valuable because many biological and chemical processes slow down or stop altogether in the cold. Psevdo-cryoryase offers a way to overcome this limitation, allowing for specific chemical transformations to occur when they otherwise wouldn’t be possible. Researchers are constantly studying its structure using techniques like X-ray crystallography to understand precisely how it achieves this cold-loving catalytic prowess. They look at the subtle movements of the amino acid chains, the interactions with water molecules (or lack thereof), and the overall three-dimensional folding of the enzyme to unlock its secrets. This detailed structural information is crucial for understanding its mechanism and for potentially engineering similar enzymes with even more desirable properties. The discovery and characterization of psevicroryase is a testament to the incredible diversity of life and the ingenious solutions that evolution has come up with to thrive in even the harshest conditions on our planet.
Why is Psevdo-Cryoryase So Important?
The significance of psevicroryase can’t be overstated, guys. Its ability to function at low temperatures makes it a potential game-changer in several fields. Imagine industrial processes that currently require high temperatures and a lot of energy to run . With enzymes like psevicroryase, we might be able to achieve similar results at much lower, more energy-efficient temperatures. This could lead to greener, more sustainable manufacturing processes. For example, in the food industry, low-temperature processing can help preserve the quality and nutritional value of products. In biotechnology, the precise breakdown of specific molecules at low temperatures could be crucial for purifying valuable compounds or for creating novel biomaterials. Furthermore, understanding psevicroryase gives us incredible insights into life in extreme environments . Many organisms, like those found in polar regions or deep-sea hydrothermal vents, have evolved unique biochemical adaptations to survive. Studying psevicroryase helps us understand the molecular basis of this resilience. It can also inform our search for life beyond Earth, in icy moons or cold planets, by giving us clues about the types of biological machinery that could operate under such conditions. The enzyme’s specificity is another key aspect of its importance. Enzymes are known for their high specificity, meaning they usually only act on one or a very limited number of substrates. Psevdo-cryoryase is no different. This specificity is vital for targeted chemical reactions, preventing unwanted side reactions and ensuring the production of pure products. This precision is something chemists have been trying to achieve for decades, and nature, in the form of enzymes like psevicroryase, often provides the best solutions. The potential applications are vast, and scientists are only just beginning to scratch the surface of what this remarkable enzyme can do. Its role in understanding the limits of life and enabling novel biotechnological solutions makes it a truly exciting area of research.
Exploring the Potential Applications of Psevdo-Cryoryase
When we talk about the potential applications of psevicroryase , the possibilities are pretty mind-blowing, seriously! One of the most exciting areas is in bioremediation . Think about oil spills or industrial waste that pollutes our environment. Many of these substances are difficult to break down, especially in cold water or soil. Enzymes that can efficiently degrade pollutants at low temperatures, like psevicroryase, could offer a natural and effective solution. Instead of harsh chemicals, we could use these cold-loving enzymes to clean up contaminated sites. This is a huge win for environmental conservation, guys! Another significant area is in the pharmaceutical industry . The precise and gentle breakdown of complex molecules is often required in drug synthesis and purification. Psevdo-cryoryase’s ability to perform these tasks at low temperatures could lead to more efficient and less wasteful production of life-saving medicines. It could also enable the manipulation of delicate drug molecules that might degrade under warmer conditions. Furthermore, consider the food processing industry . Low-temperature enzymatic treatments could be used to modify the texture, flavor, or shelf-life of food products without the need for heat, which can often degrade essential nutrients and alter the taste. This could lead to healthier, tastier, and more sustainable food options. In the realm of biotechnology and materials science , psevicroryase could be used to create novel biomaterials. For instance, it might be used to precisely cut or modify polymers at low temperatures, leading to the development of advanced materials with unique properties. Imagine biodegradable plastics that can be processed efficiently in cooler climates, or biocompatible materials for medical implants that are synthesized under gentle conditions. The enzyme’s robustness in cold environments also makes it suitable for use in diagnostics and research tools that need to operate reliably in refrigerated or frozen conditions. The ability to perform specific biochemical assays at low temperatures could enhance the sensitivity and accuracy of diagnostic tests or enable new types of research experiments. It’s truly an enzyme with a ‘cool’ future, pun intended!
The Future of Psevdo-Cryoryase Research
What’s next for psevicroryase , you ask? The future is looking incredibly bright, and the research is really heating up, ironically! Scientists are actively working on understanding its precise molecular mechanisms in even greater detail . This includes using advanced computational modeling and high-resolution structural analysis to visualize how the enzyme interacts with its substrates and how it achieves its catalytic efficiency at low temperatures. This deeper understanding is key to unlocking its full potential. Another major focus is on enzyme engineering and directed evolution . Researchers are aiming to modify psevicroryase to enhance its activity, broaden its substrate range, or even tailor it for specific industrial applications. This involves making subtle changes to its amino acid sequence to create ‘super-enzymes’ that are even more effective than the natural version. Think of it like upgrading your software for better performance! The potential for developing novel biocatalysts based on the psevicroryase scaffold is enormous. We could see custom-designed enzymes for everything from breaking down persistent organic pollutants to synthesizing complex organic molecules with high precision. Furthermore, as we continue to explore extreme environments on Earth and potentially beyond, discovering new variants of psevicroryase or similar cold-adapted enzymes will likely continue. Each new discovery adds another piece to the puzzle of how life adapts and thrives under challenging conditions. This research not only expands our knowledge of biochemistry but also provides valuable tools for tackling some of the world’s most pressing challenges, from climate change to sustainable manufacturing. The ongoing quest to understand and harness the power of psevicroryase is a testament to the ingenuity of nature and the relentless curiosity of scientists. It’s an exciting time to be following this field, and we can expect some truly groundbreaking developments in the years to come. The journey is far from over, and the best is yet to come for this ‘cool’ enzyme!